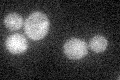
YPL186C
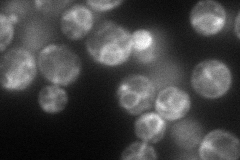
YPL186C
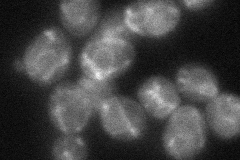
YPL186C
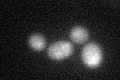
YPL186C
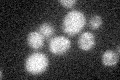
YPL186C

View description
Protein that interacts with Ulp1p, a Ubl (ubiquitin-like protein)-specific protease for Smt3p protein conjugates; detected in a phosphorylated state in the mitochondrial outer membrane; also detected in ER and nuclear envelope
Localization:
Intensity:
Fold change:
Significance:
-
C’ GFP library in SD
below threshold17.1 -
N' NOP1pr-GFP in SD
ER92.4772 -
N' TEF2pr-mCherry in SD

ER,punctate107.008 -
N' NATIVEpr-GFP in SD

mitochondria24.4082 -
N' TEF2pr-VC and Cyto-VN in SD
ER51.3087 -
C’ GFP library in SD+DTT
cytosol170.99No -
C’ GFP library in SD+H2O2
cytosol17.111No -
C’ GFP library in Starvation Media

cytosol16.930.98No -
C’ GFP library on the background of Pup2-DaMP

below threshold -
C’ GFP library on the background of CCT mutant

below threshold18.0581.05572No
